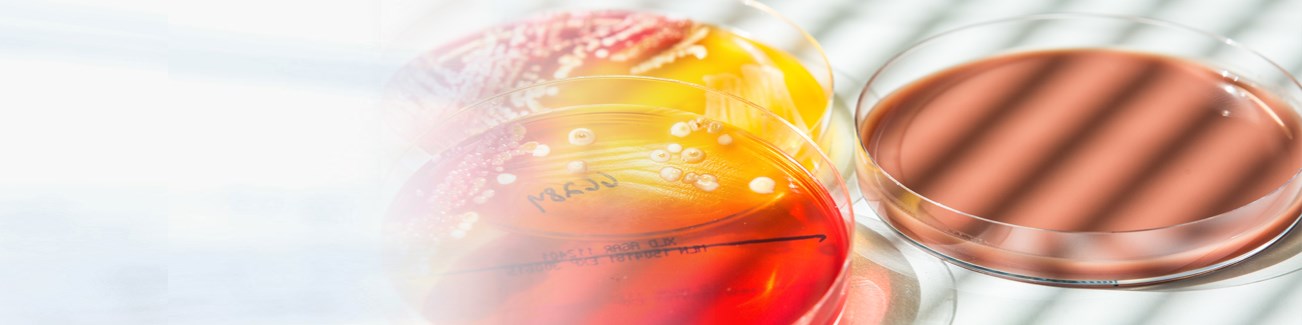

LAB HOURS: MON - THU and SAT : 9:00 AM to 9:00 PM
FRI and SUN : 9:00 AM to 6:00 PM
online services 

Parameter listings starting with "U"
For detailed information and accreditation status, please download and check the pdf.
Please note that all tests sent to Germany are done by one of our collaborating laboratories mostly within the Synlab group.
| U RNP autoantibodies part of ANA profile | Click to download |
| UGT1A1 promoter polymorphism | Click to download |
| Urea | Click to download |
| Ureaplasma urealyticum detection | Click to download |
| Uric acid | Click to download |
| Urinary concrement (stone) analysis | Click to download |
| Urinary sediment non bacterial and crystalline | Click to download |
| Urinary tract infection | Click to download |
| Urine Culture | Click to download |
| Urine electrophoresis | Click to download |
Offering a wide range of unique and state-of-the-art diagnostics services.

Specialties

Parameter Listing

Lab hours
MON - THU and SAT 9:00 AM to 9:00 PM | FRI and SUN : 9:00 AM to 6:00 PM